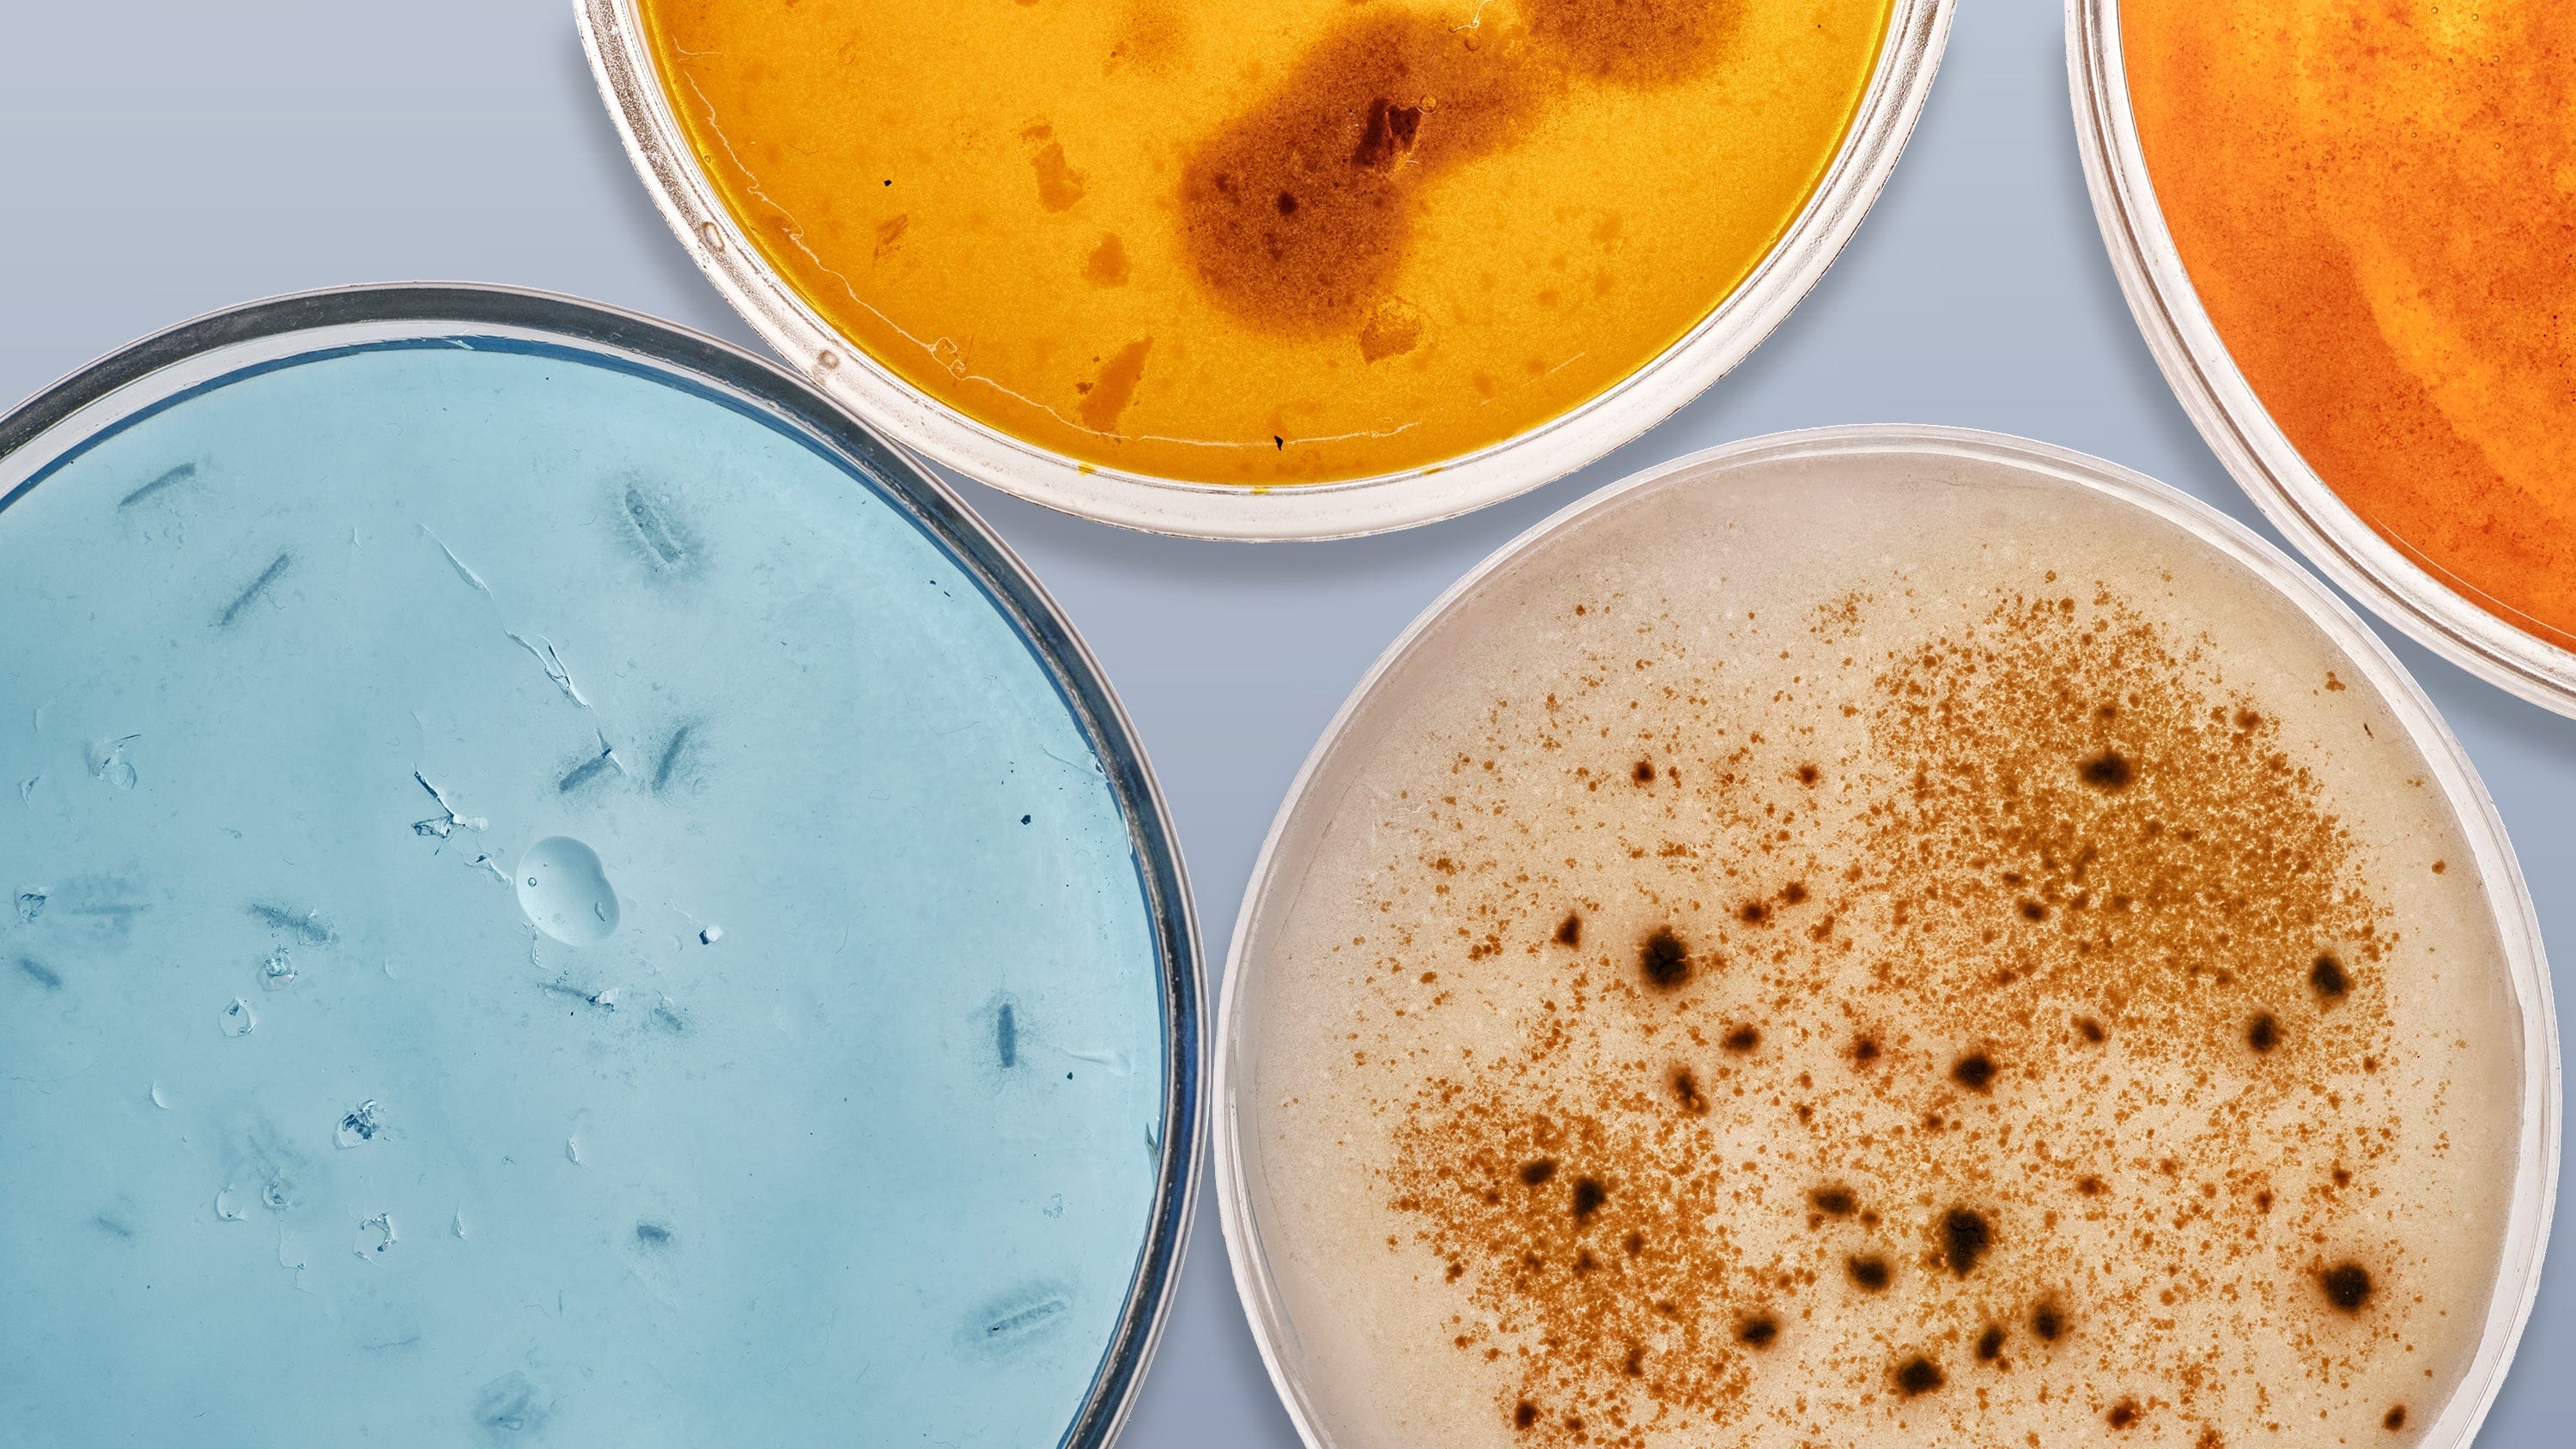

- Microscopes
- Cameras
- Lab Supplies & Equipment
- Shop By Brand
- Lab Supplies by Category
- Analyzer Consumables
- Balances
- Bags
- Beakers
- Bench Scale Bases
- Bottles
- Bottletop Burettes
- Bottletop Dispensers
- Boxes
- Blank Microscope Slides & Cover Slips
- Blood Collection
- Caps
- Carboys
- Centrifuges
- Centrifuge Tubes
- Cold Storage
- Containers
- Cryogenic Vials
- Culture Tubes
- Cylinders
- Dispensers
- Digital Dry-Baths
- ESR Products
- False Bottom Tubes
- Flat Bottom
- Funnels
- Gel Documentation
- Glassware
- Glass Test Tubes
- Histology
- Homogenizers
- Hotplates-Stirrers
- Inoculation Loops and Spreaders
- Liquid Handling Products
- Manual-Electronic Pipettors-Pipettes
- Microscope Slides
- Overhead Stirrers
- Pipette Controller (Serological Filller)
- Pipette Tips
- Plastic Test Tubes
- PCR Tubes, Strips & Plates
- Racks
- Repeater Pipettor
- Rockers
- Rotary Evaporators
- Serological Pipettes
- Shakers
- Spectrophotometers
- Syringe Tips
- Sample Tubes
- School/Classroom Supplies
- Screwcap Test Tubes
- Self-Standing
- Test Tube Racks
- Test Tubes & Vials
- Transport & Storage Tubes
- Thermal Mixers
- Transfer Pipets
- Urinalysis
- Vacuum Pumps
- Weighing Dishes
- Lab Equipment
- Balances
- Bench Scale Bases
- Centrifuges
- Digital Dry-Baths
- Gel Documentation
- Homogenizers
- Hotplates-Stirrers
- Overhead Stirrers
- Pipettors
- Rockers
- Rotary Evaporators
- Shakers
- Serological Pipettes
- Spectrophotometers
- Thermal Mixers
- Vacuum Pumps
- Liquid Handling Products
- Manual-Electronic Pipettors-Pipettes
- Pipette Tips
- Racks
- Pipette Fillers-Controllers
- Repeater Pipettor
- Syringe Tips

Cost effective products and solutions designed to improve laboratory efficiency, safety and results.
SHOP BENCHMARK SCIENTIFIC >
- Slides & Accessories
- Slides
- Cameras
- Illuminators
- Adapters
- Eyepieces / Objectives
- Bulbs
- Magnifying Lamps
- Monitors and Tablets
- View All Categories
- Adapters
- DSLR Adapters
- USB Camera Adapters
- Ring Light Adapters
- Power Adapters
- Barlow Lens
- Books & Experiments Cards
- Bags & Cases
- Bags
- Cases
- Cameras
- Circuit Board Holders
- Cleaning Kits
- Condensers
- Darkfield
- Phase Contrast Kits
- Polarizing Kits
- Dust Covers
- Eye-Guards
- Eyepieces
- 20mm
- 23mm
- 30mm
- 30.5mm
- Filters
- Microscope Filters
- Illuminator Filters
- Fluorescence Kits
- Conversion Kits
- Filter Cubes
- Focusing Racks
- Fuses
- Illuminators
- Bulbs
- LED Illuminators
- Fiber Optic Illuminators
- Fluorescent Illuminators
- Ring Lights
- Stand Lights
- Goosenecks
- Gooseneck Attachments
- Immersion Oils
- Loupes
- Magnifying Lamps
- Clamp Lamps
- Desktop Lamps
- Rolling Stand Lamps
- Mechanical Stages
- Monitors and Tablets
- Calibration Slides & Stage Micrometers
- Stage Warmers
- Stain Kits
- Stands
- Articulating Arm Stands
- Boom Stands
- Table Stands
- Tweezers
- Other Accessories
- Shop By Industry
- Shop By Industry
- Botany
- Agronomy & Forestry
- Horticulture
- Phytopathology
- Chemistry
- Biochemistry
- Biotechnology
- Cannabis
- Pharmaceutics
- Consumables
- Beer & Wine
- Cosmetics
- Food & Beverage
- Electronics
- Circuit Boards & General Electronics
- Mobile Phone Repair
- Semiconductors & Wafers
- Environmental
- Asbestos
- Ecosystem Research
- Mud Logging
- Soil Treatment
- Water Treatment
- Forensics
- Ballistics
- Fingerprint Analysis
- Genetic Identification
- Hair & Fiber Analysis
- Handwriting Analysis
- Industrial
- Aerospace
- Automotive
- Dental Lab & Production
- Glass Industry
- Industrial Inspection
- Mechanical Parts
- Paper Industry
- Petrochemical
- Plastics
- Printing Industry
- Quality Assurance & Failure Analysis
- Textiles & Fibers
- Tool Making
- Wood Production
- Jewelry & Gemology
- Engraving
- Gemology
- Jewelry Repair
- Stone Setting
- Watch Repair
- Hobby
- Coins & Collecting
- Stamps
- Modeling & Assembly
- Sculpting
- Repair
- Telescopes
- Metallurgy
- Archaeology
- Geology
- Mining
- Petrology
- Medical & Microbiology
- Anatomopathology
- Bacteriology
- Biochemistry
- Cell Culture
- Cytology
- Dental Microbiology
- Dermatology
- Dissection
- Gout & Rheumatology
- Hair & Fiber Analysis
- Hair Transplant
- Fluorescence
- Hematology & Live Blood Analysis
- Histopathology
- Mycology
- Medical Devices
- Microsurgery
- Neuropathology
- Oncology
- Parasitology
- Pathology
- Semen Analysis
- Virology
- Veterinary & Zoology
- Breeding & Semen Analysis
- Entomology
- Fecal Smears & Floats
- Marine Biology
- Ornithology
- Veterinary Medicine
- Zoology
- Shop By Industry
- Students
- Telescopes
- Buy With Prime
- Sale
Explore Our New EDUPRO Line
- Compound Microscopes
- Shop By Brand
- AmScope
- Euromex
- Omax
- Shop by Head Type
- Binocular
- Monocular
- Trinocular
- Multi-head & Training
- Shop By Specialty
- Brightfield
- Darkfield
- Phase Contrast
- Inverted
- EPIfluorescence
- Polarizing
- Digital Integrated
- Metallurgical
- Shop By Application
- Education
- Research
- Veterinary
- Compound With Digital Head
- Shop Best Sellers
- Shop All Compound
- Stereo Microscopes
- Shop By Brand
- AmScope
- Euromex
- Shop By Objective Type
- Fixed Power
- Zoom Power
- Single Lens
- Common Main Objective
- Shop By Stand Type
- Articulating Arms
- Boom Stands
- Gooseneck Stands
- Table Stands
- Other Stands
- Shop By Head Type
- Binocular
- Monocular
- Trinocular
- Simul-Focal
- Shop By Industry
- Video Inspection
- Industrial Inspection
- Microscope Heads
- Shop Stands
- Articulating Arm
- Boom Stands
- Table Stands
- Stereo With Digital Head
- Shop Best Sellers
- Shop All Stereo
- Specialized Microscopes
- Digital Microscopes
- Kids, Student Microscopes
Discover in 3D
True 3D viewing for hands-on exploration of specimens, materials, and everyday objects.
Explore the Lineup
Select a microscope below to view product details.
-
10X-30X Magnification
-
20X-40X Magnification
-
10X-30X Magnification with LED


Beginner Friendly
Design

Easy Handling & Precision

For General Science & Biology
EDU2L13 Specifications
Optical System
Greenough stereoscopic
Head
Binocular
Ocular Diameter
30.5mm
Objective Lenses
Fixed 1X/3X or 2X/4X
Focusing System
Vertical track coarse focus
Working Distance
76mm
Focus Range
40mm
Stage Diameter
95mm
Reflected Illumination
Variable-intensity LED, 1W
Transmitted Illumination
Variable-intensity LED, 1.4W
Power
AC Input: 100-240V, 50Hz/60Hz DC Output: 4.5V, 1A


Advanced
Functionality

Pro-Level
Performance

For Labs & Medical Studies
EDU2L24 Specifications
Optical System
Greenough stereoscopic
Head
Binocular
Ocular Diameter
30.5mm
Objective Lenses
Fixed 1X/3X or 2X/4X
Focusing System
Vertical track coarse focus
Working Distance
76mm
Focus Range
40mm
Stage Diameter
95mm
Reflected Illumination
Variable-intensity LED, 1W
Transmitted Illumination
Variable-intensity LED, 1.4W
Power
AC Input: 100-240V, 50Hz/60Hz DC Output: 4.5V, 1A


Professional
Grade Optics

Powerful
Illumination

For Detailed Work & Inspection
EDU3L13 Specifications
Optical System
Greenough stereoscopic
Head
Binocular
Ocular Diameter
30.5mm
Objective Lenses
Fixed 1X/3X
Focusing System
Vertical track coarse focus
Working Distance
76mm
Focus Range
40mm
Stage Diameter
95mm
Reflected Illumination
Variable-intensity LED, 1W
Transmitted Illumination
Variable-intensity LED, 1.4W
Power
AC Input: 100-240V, 50Hz/60Hz DC Output: 4.5V, 1A

What's in the Box
Includes
• One microscope
• Two stage plates: glass, reversible black/white
• Two 10X eyepieces
• One dust cover
• One AC power adapter
*Additional items may be included depending on the model.
Ready for Anything
Engineered for true depth and adaptable hands-on work.

Fit for Every User
Quick eyepiece adjustments for comfortable shared viewing.

Powerful Optics
Sharp stereo optics with true 3D depth for hands-on viewing.

Precision Controls
Easy adjustments during hands-on lessons and live demos.
Recommended Accessories
Everything you need to complete your setup.
Free Shipping on orders $149+
Same day shipping for orders within the contiguous U.S.
Easy Returns
Hassle-free 30-day return policy. 100% satisfaction guarantee.
Quality Products
5-year warranty on AmScope microscopes.
Got a question?
Speak to our team of experts and find the products you need.






























